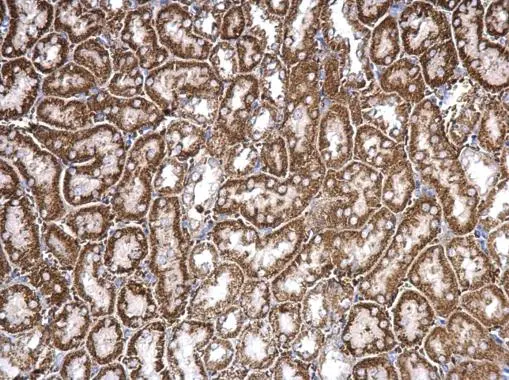
CHRDL1 antibody detects CHRDL1 protein at cytosol on mouse kidney by immunohistochemical analysis. Sample: Paraffin-embedded mouse kidney. CHRDL1 antibody (GTX117884) dilution: 1:500. 
 Antigen Retrieval: Trilogy? (EDTA based, pH 8.0) buffer, 15min

Untreated (–) and treated (+) HeLa whole cell extracts (30 μg) were separated by 10% SDS-PAGE, and the membrane was blotted with CHRDL1 antibody (GTX117884) diluted at 1:5000. The HRP-conjugated anti-rabbit IgG antibody (GTX213110-01) was used to detect the primary antibody.
CHRDL1 antibody
GTX117884
ApplicationsImmunoFluorescence, Western Blot, ImmunoCytoChemistry, ImmunoHistoChemistry, ImmunoHistoChemistry Paraffin
Product group Antibodies
ReactivityHuman, Mouse
TargetCHRDL1
Overview
- SupplierGeneTex
- Product NameCHRDL1 antibody
- Delivery Days Customer9
- Application Supplier NoteWB: 1:500-1:3000. IHC-P: 1:100-1:1000. *Optimal dilutions/concentrations should be determined by the researcher.Not tested in other applications.
- ApplicationsImmunoFluorescence, Western Blot, ImmunoCytoChemistry, ImmunoHistoChemistry, ImmunoHistoChemistry Paraffin
- CertificationResearch Use Only
- ClonalityPolyclonal
- Concentration1.52 mg/ml
- ConjugateUnconjugated
- Gene ID91851
- Target nameCHRDL1
- Target descriptionchordin like 1
- Target synonymsCHL, MGC1, MGCN, NRLN1, VOPT, dA141H5.1, chordin-like protein 1, neuralin-1, neurogenesin-1, ventroptin
- HostRabbit
- IsotypeIgG
- Protein IDQ9BU40
- Protein NameChordin-like protein 1
- Scientific DescriptionThis gene encodes an antagonist of bone morphogenetic protein 4. The encoded protein may play a role in topographic retinotectal projection and in the regulation of retinal angiogenesis in response to hypoxia. Alternatively spliced transcript variants encoding different isoforms have been described. [provided by RefSeq]
- ReactivityHuman, Mouse
- Storage Instruction-20°C or -80°C,2°C to 8°C
- UNSPSC41116161


![CHRDL1 antibody detects CHRDL1 protein at cytoplasm by immunofluorescent analysis. Sample: HeLa cells were fixed in 4% paraformaldehyde at RT for 15 min. Green: CHRDL1 stained by CHRDL1 antibody (GTX117884) diluted at 1:500. Red: alpha Tubulin, a cytoskeleton marker, stained by alpha Tubulin antibody [GT114] (GTX628802) diluted at 1:1000. Blue: Fluoroshield with DAPI (GTX30920). Scale bar= 10μm. CHRDL1 antibody detects CHRDL1 protein at cytoplasm by immunofluorescent analysis. Sample: HeLa cells were fixed in 4% paraformaldehyde at RT for 15 min. Green: CHRDL1 stained by CHRDL1 antibody (GTX117884) diluted at 1:500. Red: alpha Tubulin, a cytoskeleton marker, stained by alpha Tubulin antibody [GT114] (GTX628802) diluted at 1:1000. Blue: Fluoroshield with DAPI (GTX30920). Scale bar= 10μm.](https://www.genetex.com/upload/website/prouct_img/normal/GTX117884/GTX117884_44531_20220506_ICC_IF_w_23060519_143.webp)